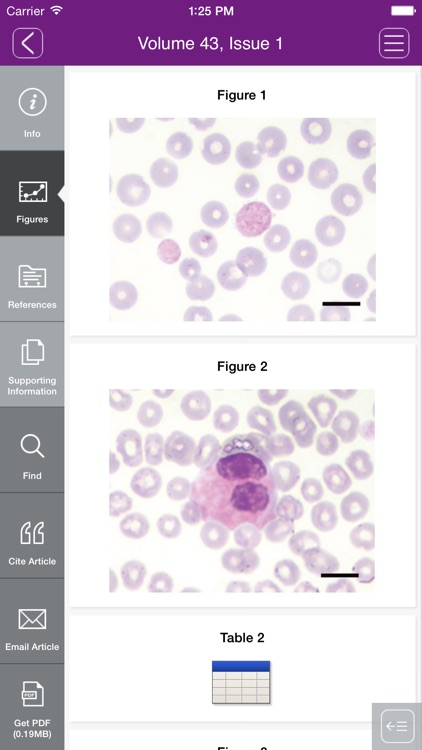
Veterinary Clinical Pathology

This app offers the latest 12 months of journal content

Veterinary Clinical Pathology



What is it about?
This app offers the latest 12 months of journal content. A full sample issue and the abstracts of all articles are available to everyone.

Veterinary Clinical Pathology is FREE but there are more add-ons
-
$169.99
Veterinary Clinical Pathology (mobile only)
App Screenshots

App Store Description
This app offers the latest 12 months of journal content. A full sample issue and the abstracts of all articles are available to everyone.
Subscribers to the journal with access through a society membership, institution, or personal subscription may link their subscription to unlock the full contents of all available issues.
CURRENT SUBSCRIBERS to Veterinary Clinical Pathology can “pair” their device with their personal or institutional subscription to enjoy full access in this iPad edition.
SUBSCRIBE IN THE APP: Annual Subscriptions (4 issues) for the iPad-only edition are available for $169.99 (US) per year. Payment is charged to your iTunes account after confirmation of purchase. Veterinary Clinical Pathology subscriptions automatically renew within 24 hours of the end of your subscription period for $169.99 (US) unless auto-renew is turned off at least 24 hours before the end of the subscription period. To turn off auto-renew, go to your iTunes account settings after purchase. Note that subscriptions cannot be cancelled during the term of the subscription, but you can still turn off auto-renew to prevent automatic renewal of your subscription. Note that any unused portion of a free trial period, if offered, will be forfeited when you purchases a subscription.
AppAdvice does not own this application and only provides images and links contained in the iTunes Search API, to help our users find the best apps to download. If you are the developer of this app and would like your information removed, please send a request to takedown@appadvice.com and your information will be removed.